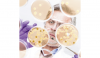

Ce qui fait sursauter en écoutant Jérôme Ferrer, c’est quand on l’entend glisser : « Vous savez, quand je suis arrivé au Québec, il y a douze ans… » Son apport à la gastronomie est tel qu’on croirait que le restaurant Europea et le mini-empire qu’il a érigé autour font partie du paysage montréalais depuis très longtemps.
Printemps 2014 - No. 177

Articles de ce numéro
Depuis la fin de l'an dernier, quelques analyses produites par des organisations, notamment l’OCDE, la Banque mondiale, et des maisons de notation telle Fitch Ratings, suscitent une certaine inquiétude quant à l’évolution du marché au Canada. Ces constats sont-ils applicables au Québec ? Assistons-nous à un mouvement baissier du marché immobilier ?
Réussissant, tant bien que mal, à maintenir le délicat équilibre de ses finances publiques en dépit d’un État plus présent que dans les autres provinces, le Québec est toutefois confronté aujourd’hui au défi colossal d’un vieillissement de sa population bien plus important et rapide qu’ailleurs. Signe de l’ampleur du défi, le gouvernement Marois a présenté en février un budget marqué du sceau de la retenue, voire de l’austérité, en dépit d’un climat fortement préélectoral.
Dans la course au pétrole, le gouvernement du Québec accélère le pas même si l’exploration et l’exploitation des ressources en hydrocarbures fossiles enfouies dans le sous-sol québécois constituent un objet de discorde.
John Engler n’en démord pas. Travailleurs et entreprises demeurent victimes de la plus lente reprise post-récession jamais enregistrée par les États-Unis depuis la Seconde Guerre mondiale. Plus de cinq ans après la crise de 2008, la plus grande économie de la planète peine à retrouver sa vitesse de croisière, faute de confiance. Dans une entrevue exclusive, l’ancien gouverneur républicain du Michigan appelle à un leadership politique fort tourné vers aujourd’hui et demain.
Le fameux « un pour cent » qui a enflammé une partie de l’opinion américaine et la jeunesse de New York en particulier (et celle de Montréal, sans véritables fondements locaux) vient de se trouver un homologue, planétaire celui-là.
Plutôt effacée mais efficace, la petite québécoise est devenue incontournable sur la scène mondiale. D’abord, elle se porte acquéreur de Logica, une européenne de près de deux fois sa taille, puis elle est projetée à l’avant-plan de l’ambitieuse réforme du système américain de santé, cruciale pour le président Obama. Le spécialiste en technologies de l’information veut encore doubler son poids d’ici cinq à sept ans, sans travestir ce qui fait sa force depuis ses débuts : la « culture CGI »
Même s’il est toujours président de la Commission canadienne d’examen des exportations de biens culturels et le sera jusqu’en août 2015, peu de gens reconnaissent Marcel Brisebois dans la rue. Pourtant, de 1971 à 1990, il fut l’intervieweur vedette de la réputée émission Rencontres de Radio-Canada.
Le Québec a sa place au panthéon de la microbiologie nord-américaine. Il y a une dizaine d’années, les hôpitaux québécois ont connu la pire épidémie de Clostridium difficile de l’histoire de la médecine au Canada et aux États-Unis.
Euromaïdan, la vague ininterrompue de manifestations en Ukraine, a commencé dans la nuit du 21 novembre 2013, après le rejet par le président ukrainien, Viktor Ianoukovitch, de la proposition d’accord d’association avec l’Union européenne (ue).